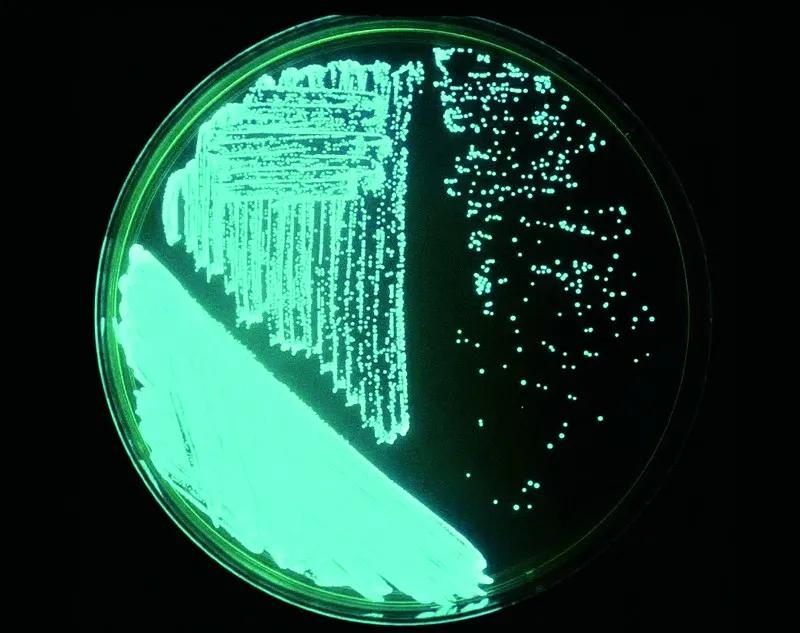
原来那片荧光海是真的存在的,荧光大海

夜晚,伴着椰风在清浅的海湾泛舟,拨动船桨,深黑的海水中倏地闪现一道蓝光将入睡的鱼群惊醒,鱼儿迅速游散,所向之处条条蓝色荧光带悄然划破水面。光带转瞬即逝,却又惊醒更多的鱼儿,于是一片片蓝光在海面发散开来,仿佛将繁星拥入海湾⋯⋯这如梦似幻的景象似乎只在描述仙境的电影中出现,没想到在波多黎各的别克斯岛,我却亲身体验了荧光海的神奇。
蚊子湾探奇
波多黎各位于西印度群岛中的大安的列斯群岛东端,包括主岛和周边小岛,是美国的海外领地。别克斯岛(Vieques)距主岛东岸10余公里,东西长约33公里,南北宽7公里,是波多黎各第二大岛。美国海军曾长期驻扎在这里,2003年撤离后岛上约2/3面积划为美国国家自然保护区。
我从主岛东部的法哈多港(Fajardo)乘快艇出发,经过1个多小时风浪颠簸后登陆别克斯岛北部的伊莎贝尔塞贡达镇(Isabel Segunda)。到达时已近黄昏,不等从晕船的痛苦中回过神,我就赶紧钻进一辆出租车直奔南部的埃斯佩兰萨(Esperanza),传说中的荧光海就位于其东部约3公里的蚊子湾(Mosquito Bay)。夜幕悄然降临,沿途不时出现三五个当地少年骑着无鞍的马匹悠闲散步,温润清新的海风扑面而来,心情也随之平静下来。
由于到达较晚,当日的荧光海生态游已经满员。我抱着试试看的心态多等了一会儿,竟幸运地捡了个漏。坐上一辆巴士,在漆黑的土路上狂奔,不一会儿来到海湾边,一艘电动船正缓缓向我们驶来。四周没有任何灯光,只能看见北面的天空泛出些许红晕,那应该是伊莎贝尔塞贡达的灯光吧。船近了,船工打开大电筒照着水面,我才发现蚊子湾很清浅,和想象中的海湾不同,空气中也没有一丝腥味。紧盯着水面看了一会儿,没发现任何特殊之处,荧光在哪里呢?
带着疑问上了船,在船头坐下,马达启动,向着海湾中部驶去。半个月亮高悬在空中,月光洒落在水面,泛起银色的波影。看荧光海最好在无月或新月时,满月太过明亮,几乎看不到荧光效果。行进中,船头两侧的波浪隐隐出现微弱的光亮,但在月光下我无法辨别是否就是传说中的“荧光”。正当有些失落,不知何处飘来一朵云将月亮藏了起来,波浪中的微光立刻明显起来。这光亮不同于人造光源从某一点射出,而是微弱地自水中溢出,泛着淡蓝的光晕,用“流光溢彩”形容再恰当不过。这无疑就是神奇的荧光了。
是谁点亮了海水
这片海水真的能发光?其实不然。荧光实际是由水中一种单细胞甲藻——巴哈马麦甲藻(Pyrodinium bahamense)发出的,其拉丁属名前缀“pyro”的意思即“火”。甲藻是一类非常奇特的生物,说它是动物,它又同植物一样具有叶绿素等光合色素,能进行光合作用,而且绝大多数种类同植物一样具有由纤维素构成的细胞壁;说它是植物,又有能帮助其游动的双鞭毛,一些种类还具有能感光的眼点。传统动物学和植物学教科书中都有介绍甲藻的章节,让人对它的分类感到模棱两可,直到人们在甲藻中发现了球胞型和丝状藻体后,才将其划入植物界。
巴哈马麦甲藻细胞大致呈球形,直径略大于40微米,细胞壁由多块小板构成,细胞中部有一条环状横沟,有两条顶生鞭毛。这种浮游藻类在蚊子湾每升海水里多达19万个,是全球发光甲藻密度最高的海湾,因而也是世界上最亮的荧光海。

巴哈马麦甲藻是一种具有双鞭毛的单细胞植物,其发光是为惊吓捕食者或引来捕食者的天敌进行的自我保护。

夜晚在别克斯岛的蚊子湾荡舟,水中的发光甲藻点亮了海面。
对于巴哈马麦甲藻的发光机制人们至今没有完全弄明白,但有一点可以肯定,要使其发光,首先需对细胞施加外力,比如划动船桨。外力使细胞的液泡膜发生超极化,氢离子得以进入液泡形成一个酸性环境,促使荧光素酶活性提高,催化荧光素脱离结合蛋白。被活化的荧光素继而与氧气结合,生成氧化荧光素,并发出波长在474〜476纳米间的蓝色光。这就是水中荧光的基本来历。

拍击海水出现星光闪耀是因为外力激活了甲藻体内的荧光素
船慢慢驶向海湾另一侧,昏暗中我看见岸边有约5米高的树丛,船长打开一支远光电筒,水面上出现了密集交错的支柱根,果然是红树林。随着电筒光亮的游移,我发现整个蚊子湾的水域(64万平方米)几乎被红树林包围。可别小看这片红树林,它们与荧光海有着极紧密的联系。红树的枯枝落叶掉入水中后被水里的细菌分解利用,合成维生素B12并释放到海水中,而维生素B12恰是发光甲藻生存所必须的。高浓度的维生素B12催生出高浓度的甲藻,在很大程度上,是这条微妙的关系链维系着这片神奇的荧光海。

蚊子湾是全球发光甲藻浓度最高的海湾,茂密的红树林和狭窄的出口为甲藻繁殖提供了绝佳环境。
船长让我们特别注意蚊子湾狭窄的出口,它使湾内海水与大海的交换速率保持在一个较低水平。这里水位浅,日照充足,蒸发量相对较大,海水终年温暖,这些因素综合在一起,才得以塑造出世界上最大最亮的荧光海。据说,15世纪西班牙人初次见到这片荧光海又惊又怕,以为是“恶魔之作”,他们将土石倾倒在海湾口,以期隔绝海水消除“恐怖”,殊不知此举反而令荧光海更加美丽。
此刻月亮又探出了头,船长关掉马达,任船漂在水面上,开始为我们讲解天上的星座。突然,他使劲儿跺起脚来,静夜里惊得几条鱼儿跃出水面,留下一小片荧光。船长故作神秘地停了一会儿,又更用力地踩踏甲板,砰砰声响彻整个海湾。坐在船头的我被眼前的景象惊呆了:黑沉沉的海水中出现一道道急速移动的蓝光带,不断向四周延伸,冲撞,激荡,光亮比船桨激起的更加耀眼,仿佛无数支蓝色荧光笔在黑幕上肆意涂鸦,然后画下一个巨大的休止符,顷刻间,所有光亮和色彩都在画布上消失了。
目前全球稳定的荧光海有六七处,除了别克斯蚊子湾,在波多黎各主岛东北部以及牙买加等地也能看到。以前能欣赏的地方更多,比如夏威夷和巴哈马,这两处海湾出口由于人工拓宽,导致甲藻密度下降,最终失去了梦幻的光亮。荧光海的消失主要与人类活动造成的海水污染有关。波多黎各主岛西南部曾有一处荧光海可与蚊子湾媲美,但因水体污染,如今亮度只及后者的1/10。

在波多黎各主岛东北部拉哈斯的拉帕格拉(Laparguera)海滩,游客在“星海”中畅游。

发光微生物为马尔代夫的瓦度海滩披上一层梦幻面纱
当海水发生富氧化甚至暴发赤潮时,一些发光藻类大量繁殖,也会产生海水发光现象。2011年9月底的美国加州圣迭哥海滩,人们在夜间漫步时发现破碎的海浪中泛出莹莹蓝光,一时间媒体竞相报道,冲浪爱好者们更是抓住这一千载难逢的机会体验荧光冲浪的快感。不过,这种赤潮型荧光海持续时间不长,发生的海域也不固定,远没有常态荧光海的吸引力大。

当赤潮暴发,海水中的发光藻类富集,也会产生海水发光现象。图为英国威尔士安格尔西岛的荧光海岸。
生命的光芒
要想见识更壮丽的荧光海景象,还得到远离海岸的大洋中去。17世纪以来,商船的航海日志中不断提到“银海”现象,而且超过70%的“银海”都出现在印度洋西北部。1995年1月25日,英国商船“利马号”在这一海域驶入了“银海”:
“格林威治时间18点(当地时间21点)。无月的夜晚。索马里海岸以东150海里处,地平线上泛起白色的光晕。航行15分钟后,整艘船被发出均匀奶白色光亮的海水包围。这一光亮几乎覆盖了整个海面,向各个方向延伸至地平线⋯⋯船仿佛在雪地中航行,又似在云端滑行⋯⋯船首和船尾的浪花却泛出黑色,深黑色的油斑从船侧漂过。后来在信号灯的照射下发现,这些‘油斑’其实是淡绿色的大型海藻,它们在发白的海水中显出黑色,令人称奇。”
哈维氏弧菌(Vibrio harveyi)是“银海”的始作俑者。这种细菌和棕囊藻共生,在海水中达到一定浓度后开始集体发光,大有一呼百应之势。印度洋西北部海域终年温暖,加之从深海涌起的上升流带来大量的营养物质,有利于细菌增殖,所以大多数“银海”都发生在这一海域。和甲藻不同的是,哈维氏弧菌能够持续发光,虽然每个细菌发出的光亮不及甲藻,但凭借数量大、覆盖面积广,连太空中的卫星都能监测到“银海”的光芒。这一发现刊登在2005年的《美国国家科学院院刊》上。

卫星监测到印度洋西北部长达250公里的“银海”现象,发光细菌哈维氏弧菌(下图)是其塑造者。
哈维氏弧菌是一种颇有“心计”的细菌。虽说与棕囊藻的小日子过得不错,却更觊觎鱼类等动物的消化道。于是它们采用长时间发光的策略,吸引鱼类前来吞食棕囊藻,这样就能如愿以偿地抵达消化道,过上更加奢华的生活了。谁能想到,这壮丽的“银海”竟满是哈维氏弧菌的小算盘。
其实发光生物在海洋中广泛存在,甲藻、细菌、栉水母、刺胞动物、毛颚动物、环节动物、软体动物、甲壳动物、棘皮动物,以及生活在海底的鱼,仅是海洋发光生物的部分名单。相比而言,陆地环境中的发光生物种类可谓小巫见大巫,而淡水环境中除了少数昆虫幼虫外,也几乎没有发光的。海洋中普遍存在的弱光和黑暗生境、比河湖更为清澄的水体,以及多种生物间的相互作用(如捕食),为生物发光现象的形成提供了绝佳温床。
据科学研究,现存海洋生物中至少有40多个生物类群的发光本领是独立起源的,这似乎暗示着发光对于海洋生物的重要性,而且这一本领应该也不难获得。的确,生物发光主要需要两个要素:一是发光原料——统称为荧光素,二是催化剂——荧光素酶或发光蛋白,在适宜的条件下两相结合便能发出光亮。有趣的是,作为发光原料的荧光素在各大生物类群中的变化并不多,真正变化多端的是催化剂。

日本渔民在富士湾捕获到大量荧光乌贼

发光生物广泛存在于海洋中。图片依次为花笠水母、灯塔水母、栉(zhì)水母、鮟鱇鱼、荧光乌贼。





发光珊瑚为漆黑的海底世界带来点点光亮

虽然发光的基本原理相似,但各种生物发光的目的千差万别——防御、吸引猎物、通讯、求偶,甚至是为了进入其它动物的消化道而求被吞食,一种生物发光的目的也往往不是单一的。发光生物的一大特征是与同种其他个体或别种生物有着密切的交流和联系,“闷声发财”的寄生生物几乎没有发光现象。由此可见,生物发光现象不大可能是代谢的副产品,而是有着重要的生态学意义。

本文选自2020年8月刊